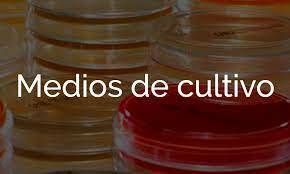
Beijerinck y Winogradsky

-
 En su “De rerum natura” hace varias alusiones a “semillas de enfermedad”
En su “De rerum natura” hace varias alusiones a “semillas de enfermedad” -
Invención de las primeras lentes para corregir la visión, algunas ideas sobre aspectos de la física óptica de las lentes de aumento, pero no encontraron una aplicación inmediata. Se dice que Galileo hizo algunas observaciones “microscópicas” invirtiendo su telescopio a partir de lentes montadas en un tubo,
-
 En su libro “De contagione et contagionis” dice que las enfermedades contagiosas se deben a “gérmenes vivos” que pasan de diversas maneras de un individuo a otro. "
En su libro “De contagione et contagionis” dice que las enfermedades contagiosas se deben a “gérmenes vivos” que pasan de diversas maneras de un individuo a otro. " -
 Se debe a Constantijn Huygens, quien relata que el inglés Cornelis Drebbel tenía en su taller un instrumento magnificador, que recibió el nombre de microscopium en l625, en la Accademia dei Lincei, de Roma.
Se debe a Constantijn Huygens, quien relata que el inglés Cornelis Drebbel tenía en su taller un instrumento magnificador, que recibió el nombre de microscopium en l625, en la Accademia dei Lincei, de Roma. -
 "comerciante holandés de tejidos, descubrimiento de los microorganismos, en su pasión por pulir y montar lentes casi esféricas sobre placas de oro, plata o cobre.
"comerciante holandés de tejidos, descubrimiento de los microorganismos, en su pasión por pulir y montar lentes casi esféricas sobre placas de oro, plata o cobre.
Fabricó unos cuatrocientos microscopios simples, con los que llegó a obtener aumentos de casi 300 diámetros. -
 Sus magníficas dotes de observador le llevaron asimismo a describir protozoos (como Giardia, que encontró en sus propias heces la estructura estriada del músculo, la circulación capilar, a descubrir los espermatozoides y los glóbulos rojos.
Sus magníficas dotes de observador le llevaron asimismo a describir protozoos (como Giardia, que encontró en sus propias heces la estructura estriada del músculo, la circulación capilar, a descubrir los espermatozoides y los glóbulos rojos. -
 "Describio La estructura celular de las plantas (Micrographia, ), acuñando el término
"Describio La estructura celular de las plantas (Micrographia, ), acuñando el término
célula" -
"Describió: Los hongos filamentosos"
-
Había acuñado la expresión “Omne vivum ex ovo" tras comprobar que los insectos y nematodos procedían de huevos puestos por animales adultos de su misma especie.
-
"Descubrió que en una gota de agua de estanque pululaba una asombrosa variedad de pequeñas criaturas a las que denominó “animálculos”. "
-
"descubre las bacterias, por lo que se considera el “padre de la
Microbiología”. " -
"Demostró que los “infusorios” no aparecían en muestras de maceraciones animales o vegetales sometidas durante tiempo suficiente a ebullición en frascos herméticamente cerrados, pero volvían a aparecer si se practicaban agujeros en el recipiente"
-
Los preformacionistas. replicó -con argumentos vitalistas muy propios de la época- que el calor había destruido la “fuerza vegetativa” de las infusiones y había cambiado la “cualidad” del aire dentro de los frascos.
-
 Se desarrollaron las lentes acromáticas
Se desarrollaron las lentes acromáticas -
demostró que cierta enfermedad del gusano de seda (mal di segno), se debía a un hongo (Botrytis bassiana).
-
Genero un método seguro para refutar la teoría abiogénica: calentó maceraciones en frascos a los que se había eliminado
previamente el aire, -
habían sugerido que las levaduras eran las causantes de la fermentación alcohólica
-
Descubrió la asociación de un hongo con una enfermedad humana de la piel.
-
 Planteó la teoría de que las enfermedades infecciosas están causadas por seres vivos invisibles.
Planteó la teoría de que las enfermedades infecciosas están causadas por seres vivos invisibles. -
Había realizado importantes confirmaciones a la “teoría mineral” sobre la nutrición de las plantas, enfrentándose a la “teoría del humus” se consideraba a las levaduras como plantas microscópicas.
-
 Demostró que los agentes de la fermentación láctica eran microorganismos.
Demostró que los agentes de la fermentación láctica eran microorganismos. -
 (“Expériences rélatives aux générations dites spontanées”) comunica sus sencillos y elegantes experimentos: calentó infusiones en matraces de vidrio a los que estiraba lateralmente el cuello, haciéndolo largo, estrecho y sinuoso, y dejándolo sin cerrar, de modo que el contenido estuviera en contacto con el aire; tras esta operación demostró que el líquido no desarrollaba microorganismos, con lo que eliminó la posibilidad de que un “aire alterado” fuera la causa de la no aparición de gérmenes.
(“Expériences rélatives aux générations dites spontanées”) comunica sus sencillos y elegantes experimentos: calentó infusiones en matraces de vidrio a los que estiraba lateralmente el cuello, haciéndolo largo, estrecho y sinuoso, y dejándolo sin cerrar, de modo que el contenido estuviera en contacto con el aire; tras esta operación demostró que el líquido no desarrollaba microorganismos, con lo que eliminó la posibilidad de que un “aire alterado” fuera la causa de la no aparición de gérmenes. -
publica otro informe en el que explica cómo se pueden capturar los “cuerpos organizados” del aire con ayuda de un tubo provisto de un tapón de algodón como filtro, y la manera de recuperarlos para su observación microscópica.
-
 encontró que en la sangre de vacas afectadas aparecían grandes cantidades de microorganismos a los que llamó bacteridios; además, logró inducir la enfermedad experimentalmente en vacas sanas, inoculándoles muestras de sangre infectada.
encontró que en la sangre de vacas afectadas aparecían grandes cantidades de microorganismos a los que llamó bacteridios; además, logró inducir la enfermedad experimentalmente en vacas sanas, inoculándoles muestras de sangre infectada. -
En sus Études sur le vin resume sus hallazgos al respecto de la fermentación alcohólica a ciertos tipos de levaduras.
INAGURANDO LA MICROBIOLOGIA APLICADA -
 llega finalmente, a identificar al protozoo Nosema bombycis como el responsable de la epidemia, y por medio de una serie de medidas de control, ésta comienza a remitir de modo espectacular.
llega finalmente, a identificar al protozoo Nosema bombycis como el responsable de la epidemia, y por medio de una serie de medidas de control, ésta comienza a remitir de modo espectacular. -
 creía que las infecciones se debían a gérmenes presentes en el aire, comprobó que la aplicación de compuestos como el fenol o el bicloruro de mercurio en el lavado del instrumental quirúrgico, de las manos y de las heridas, disminuía notablemente la frecuencia de infecciones post-quirúrgicas y puerperales.
creía que las infecciones se debían a gérmenes presentes en el aire, comprobó que la aplicación de compuestos como el fenol o el bicloruro de mercurio en el lavado del instrumental quirúrgico, de las manos y de las heridas, disminuía notablemente la frecuencia de infecciones post-quirúrgicas y puerperales. -
consiguió aislar los bacilos filtrando sangre de animales carbuncosos.
-
"había descrito las propiedades antibióticas de ciertos cultivos de hongos (Penicillium glaucum) contra las bacterias e introdujo en Microbiología el concepto de antagonismo"
-
Tiñó bacterias con pirocarmín, En años sucesivos se fueron introduciendo el azul de metileno, la fuchsina, y el violeta cristal.
-
Identificó distintos microorganismos responsables de diferentes clases de procesos fermentativos.
-
Por medo de la técnica de cultivo puro logró, el primer aislamiento y propagación in vitro del bacilo del ántrax (Bacillus anthracis), consiguiendo las primeras microfotografías sobre preparaciones secas, fijadas y teñidas con azul de metileno.
-
 Aplicó su sistema de esterilización por calentamiento discontinuo (hoy conocida precisamente como tindalización), que evidenció la existencia de formas microbianas de reposo muy resistentes al calor,.
Aplicó su sistema de esterilización por calentamiento discontinuo (hoy conocida precisamente como tindalización), que evidenció la existencia de formas microbianas de reposo muy resistentes al calor,. -
Realizó diluciones secuenciales de cultivos mixtos, hasta lograr muestras en las que existía una sola célula
-
 desarrolló el objetivo de inmersión en aceite.
desarrolló el objetivo de inmersión en aceite. -
introducción del concepto de simbiosis
-
 "confirmaron que las esporas son formas diferenciadas a partir de los bacilos, y más resistentes que éstos a una variedad de agentes, demostración de que la enfermedad se podía transmitir sucesivamente a ratones sanos inoculándoles bacilos en cultivo puro, obtenidos tras varias transferencias en medios líquidos."
"confirmaron que las esporas son formas diferenciadas a partir de los bacilos, y más resistentes que éstos a una variedad de agentes, demostración de que la enfermedad se podía transmitir sucesivamente a ratones sanos inoculándoles bacilos en cultivo puro, obtenidos tras varias transferencias en medios líquidos." -
siguiendo una sugerencia de su mujer Fanny, introdujo el agar-agar (polisacárido extraído de algas rojas
-
desarrollan su método de ácido-alcohol resistencia para teñir Mycobacterium tuberculosis.
-
“Die Äthiologie der Tuberkulose”,
- El microorganismo debe de estar presente en todos los individuos enfermos.
- El microorganismo debe poder aislarse del hospedador y ser crecido en cultivo puro.
- La inoculación del microorganismo crecido en cultivo puro a animales sanos debe provocar la aparición de síntomas específicos de la enfermedad en cuestión.
- El microorganismo debe poder ser reaislado del hospedador infectado de forma experimental.
-
En la Escuela Alemana se aislaron los agentes productores del cólera asiático
-
se aislaron los agentes productores de la difteria
-
 establece una tinción de contraste que permite distinguir dos tipos bacterianos en función de sus reacción diferencial de tinción y que, como se vería mucho más tarde, reflejaba la existencia de dos grupos de bacterias con rasgos estructurales distintivos.
establece una tinción de contraste que permite distinguir dos tipos bacterianos en función de sus reacción diferencial de tinción y que, como se vería mucho más tarde, reflejaba la existencia de dos grupos de bacterias con rasgos estructurales distintivos. -
había señalado que los microorganismos del suelo podían incorporar nitrógeno molecular directamente del aire.
-
 nucleada en el Instituto Pasteur, se concentró en los estudios sobre los procesos infectivos, la inmunidad del hospedador, y la obtención de vacunas, sobre todo a raíz de la vacuna antirrábica ensayada por Pasteur. contribuyendo al nacimiento de la Inmunología
nucleada en el Instituto Pasteur, se concentró en los estudios sobre los procesos infectivos, la inmunidad del hospedador, y la obtención de vacunas, sobre todo a raíz de la vacuna antirrábica ensayada por Pasteur. contribuyendo al nacimiento de la Inmunología -
Aislaron los agentes productores del tétanos
-
Aislaron los agentes productores de la neumonía
-
Aislaron los agentes productores de la meningitis
-
 "ayudante de Koch, sustituyó las engorrosas bandejas de vidrio cubiertas con campanas, usadas hasta entonces para los
"ayudante de Koch, sustituyó las engorrosas bandejas de vidrio cubiertas con campanas, usadas hasta entonces para los
cultivos sólidos por un sistema manejable de placas de cristal planas, que se conoce como cajas de Petri" -
Desarrollo de los medios selectivos y de enriquecimiento,investigaciones, sobre bacterias implicadas en procesos biogeoquímicos y poseedoras de características fisiológicas distintivas (quimioautótrofas, fijadoras de nitrógeno
Desarrollo de los medios selectivos y de enriquecimiento,investigaciones, sobre bacterias implicadas en procesos biogeoquímicos y poseedoras de características fisiológicas distintivas (quimioautótrofas, fijadoras de nitrógeno -
el primero en aislar una bacteria capaz de fijar nitrógeno atmosférico (Clostridium pasteurianum) y en explicar el ciclo del nitrógeno en la naturaleza
-
 Se logra visualizar flagelos bacterianos por medio de su técnica de impregnación argéntica.
Se logra visualizar flagelos bacterianos por medio de su técnica de impregnación argéntica. -
 Introdujo el uso de indicadores de pH, incorporados en los medios, lo cual permitía revelar la producción de acidificaciones por fermentación en ciertas bacterias.
Introdujo el uso de indicadores de pH, incorporados en los medios, lo cual permitía revelar la producción de acidificaciones por fermentación en ciertas bacterias. -
 Había observado que la enfermedad del mosaico del tabaco podía ser reproducida experimentalmente usando el fluido que atravesaba los filtros de porcelana que normalmente retenían a las bacterias, pero siendo incapaz de aislar y crecer el supuesto microorganismo, abandonó la investigación.
Había observado que la enfermedad del mosaico del tabaco podía ser reproducida experimentalmente usando el fluido que atravesaba los filtros de porcelana que normalmente retenían a las bacterias, pero siendo incapaz de aislar y crecer el supuesto microorganismo, abandonó la investigación. -
Se aislaron los agentes productores de la peste
-
Estudios de los ciclos infectivos de agentes de peste vacuna africana
-
Obtuvo, a partir de levaduras, una preparación enzimática (zimasa) que era capaz de realizar la misma transformación de “fermentación” que las células vivas.
-
 Descubridor de Azotobacter como bacteria aerobia fijadora de vida libre
Descubridor de Azotobacter como bacteria aerobia fijadora de vida libre -
Pudieron desentrañar los ciclos infectivos de agentes de enfermedades tropicales no bacterianas que la potencia colonial se encontró en ultramar: malaria.
-
Descripción de ciclos infectivos de agentes de enfermedad del sueño
-
 Demostró por métodos químicos que, en efecto, Azotobacter incorpora nitrógeno de la atmósfera mientras crece.
Demostró por métodos químicos que, en efecto, Azotobacter incorpora nitrógeno de la atmósfera mientras crece. -
 Probó sistemáticamente derivados del atoxilo, informó de que el compuesto 606 (salvarsán) era efectivo contra la sífilis. Aunque el salvarsán presentaba algunos efectos colaterales, fue durante mucho tiempo el único agente disponible contra enfermedades producidas por espiroquetas, y sirvió para ilustrar brillantemente la validez del enfoque de la llamada quimioterapia.
Probó sistemáticamente derivados del atoxilo, informó de que el compuesto 606 (salvarsán) era efectivo contra la sífilis. Aunque el salvarsán presentaba algunos efectos colaterales, fue durante mucho tiempo el único agente disponible contra enfermedades producidas por espiroquetas, y sirvió para ilustrar brillantemente la validez del enfoque de la llamada quimioterapia. -
 Acuñó el término bacteriófago, y supuso correctamente que el fenómeno de lisis por estos agentes debía de estar ampliamente difundido entre las bacterias.
Acuñó el término bacteriófago, y supuso correctamente que el fenómeno de lisis por estos agentes debía de estar ampliamente difundido entre las bacterias. -
1ª edición del sistema de taxonomía bacteriana En cuanto a la nomenclatura, no fue hasta 1958 en que cuajó un Código Internacional de Nomenclatura Bacteriológica.
-
Describen por primera vez el fenómeno de lisogenia
-
Primera visualización de un virus se debe a las observaciones a microscopio ultravioleta
-
En conexión con la poderosa compañía química I.G. Farbenindustrie, inició un ambicioso proyecto de búsqueda de nuevos agentes quimioterápicos, siguiendo el esquema de Ehrlich.
-
 Al atribuir a una sustancia química concreta (la penicilina) la acción inhibidora sobre bacterias producida por el hongo Penicillium notatum. Mostrando que no todas las especies bacterianas eran igualmente sensibles a la penicilina. Las dificultades técnicas para su extracción, junto al hecho de que el interés de la época aún estaba centrado sobre las sulfamidas.
Al atribuir a una sustancia química concreta (la penicilina) la acción inhibidora sobre bacterias producida por el hongo Penicillium notatum. Mostrando que no todas las especies bacterianas eran igualmente sensibles a la penicilina. Las dificultades técnicas para su extracción, junto al hecho de que el interés de la época aún estaba centrado sobre las sulfamidas. -
 Descubre la acción del rojo de prontosilo frente a neumococos hemolíticos dentro del hospedador, pero señala que esta droga es inactiva sobre bacterias creciendo in vitro. La explicación la suministra el matrimonio Tréfouël, del Instituto Pasteur, al descubrir que la actividad antibacteriana depende de la conversión por el hospedador en sulfanilamida.
Descubre la acción del rojo de prontosilo frente a neumococos hemolíticos dentro del hospedador, pero señala que esta droga es inactiva sobre bacterias creciendo in vitro. La explicación la suministra el matrimonio Tréfouël, del Instituto Pasteur, al descubrir que la actividad antibacteriana depende de la conversión por el hospedador en sulfanilamida. -
Avances más significativos en el estudio de la composición y estructura de los virus se inician con la purificación y cristalización, del virus del mosaico del tabaco -TMV-
-
 Realiza las primeras cartografías genéticas en cromosomas de Neurospora, durante su estancia en el laboratorio californiano de Morgan; este último, propugnador de la “teoría de los genes”
Realiza las primeras cartografías genéticas en cromosomas de Neurospora, durante su estancia en el laboratorio californiano de Morgan; este último, propugnador de la “teoría de los genes” -
 se realiza la primera fotografía de un virus a microscopio electrónico
se realiza la primera fotografía de un virus a microscopio electrónico -
"La purificación de la penicilina, comprobándose entonces su gran efectividad contra infecciones bacterianas, sobre todo
de Gram-positivas, y la ausencia de efectos tóxicos para el hospedador." -
 Aíslan mutantes autotróficos de Neurospora, con lo que se inicia el estudio de la base bioquímica de la herencia, y convierten a este hongo en una valiosa herramienta de trabajo en esta línea de investigación.
Aíslan mutantes autotróficos de Neurospora, con lo que se inicia el estudio de la base bioquímica de la herencia, y convierten a este hongo en una valiosa herramienta de trabajo en esta línea de investigación. -
 "Descubren la estreptomicina, producida por Streptomyces griseus, siendo el primer ejemplo de antibiótico de
"Descubren la estreptomicina, producida por Streptomyces griseus, siendo el primer ejemplo de antibiótico de
amplio espectro. " -
"años que siquieron al término de la segundad guerra mundial vieron la descripción de 96 antibióticos distintos producidos
por 57 especies de microorganismos, principalmente Actinomicetos." -
 Desarrollar por primera vez un método para la multiplicación virásica sobre cultivos de tejidos de mamíferos, técnica que fue perfeccionada más tarde por el equipo de Renato Dulbecco.
Desarrollar por primera vez un método para la multiplicación virásica sobre cultivos de tejidos de mamíferos, técnica que fue perfeccionada más tarde por el equipo de Renato Dulbecco. -
Relaciones entre los ciclos lítico y lisogénico de los fagos no fueron aclaradas hasta sus estudios
-
Al obtenerse compuestos semisintéticos por modificación química de antibióticos naturales"
Looking for a timeline maker?
Create timelines for projects, roadmaps, history, lessons, legal cases, and stories with Timetoast. Timetoast is a timeline maker for work, school, research, and stories.